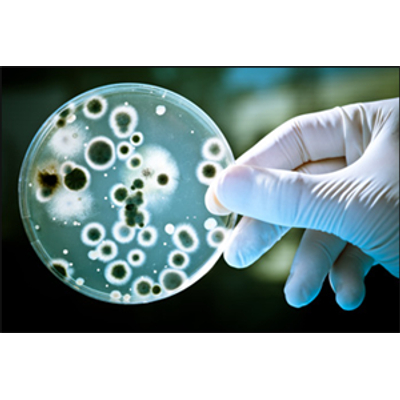

Indoor Air Quality (IAQ) Services
Indoor Air Quality (IAQ) refers to the air quality within and around buildings, especially as it relates to the health and comfort of their occupants. The Insurance Information Institute estimates that $3 billion in mold claims were paid out in 2002.IAQ can be affected by :
- Mold and Bacteria
- Gases including carbon monoxide, radon, and volatile organic compounds (VOCs)
- Particulates that can induce adverse health conditions
Inexperienced consultants may employ individual measures to provide good IAQ, without a rigorous understanding of the project-specific impacts of these measures or an efficient assessment of IAQ priorities. IAQ problems that get out of hand or are inaccurately managed can be quite costly in terms of:
- Legal costs and bad publicity
- Lost work time
- Lost use of buildings
- Expensive building or mechanical system repairs
- Health-care expenses
The potential reductions in costs from providing better IAQ in non-industrial workplaces in the U.S. are estimated to be in the high "tens of billions of dollars annually" (EPA 1989; Fisk 2000; Mendell et al. 2002)
- Improving the Health of Workers in Indoor Environments
The job of controlling Indoor Air Quality in buildings continues to get more difficult as new IAQ Health and Safety regulations are enacted by the EPA, OSHA and local governments.
You want answers that are readily available and easily applicable. AtZimmetry, we provide confidential and accurate information and tools that building owners, architects and design engineers can use to achieve adequate IAQ thru:
- Responding on short notice
- Continuous education of consultants and vast project experience
- Knowledge of applicable regulations
- State-of-the-art technology and up-to-date assessment techniques
- Proper frequency of status reports and meetings
- Personalized assistance facilitating the customers` involvement in the project
